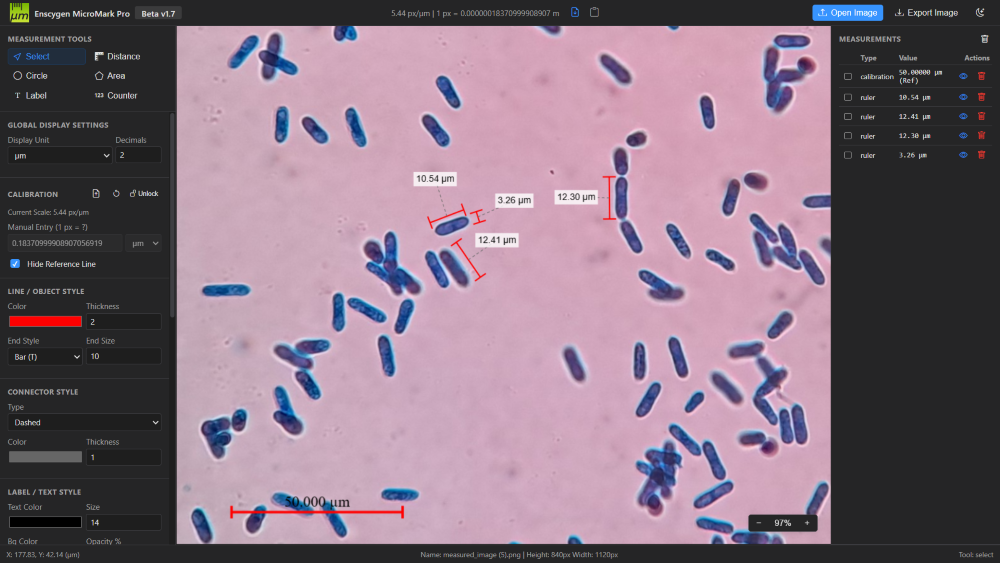

MicroMark Pro
Precision Image Analysis & Microscopy Tools
A lightweight, powerful, and completely web-based image analysis tool. No installation required — just open, upload, and start measuring with professional-grade accuracy directly in your browser.
Smart Dynamic Units & Scaling.
Work in the unit that makes sense for your research. Support for nanometers (nm), micrometers (µm), millimeters (mm), centimeters (cm), meters (m), and raw pixels (px). Switch units and watch measurements convert automatically.
Core Capabilities
Precision Scaling
Draw a reference line over a known distance, manually enter scale, or import/export calibration JSONs to share settings with colleagues.
Measurement Suite
Go beyond lines. Use Rulers, Circles, Polygons (Area/Perimeter), Counters, and Text Labels for comprehensive spatial analysis.
Real-Time Statistics
Instantly calculate Sum, Mean, SD, and Range. Simply check measurement boxes to analyze variance across your samples.
Professional Export
Export high-resolution images with measurements, scale bars, and annotations burned in. Ready for lab reports and thesis papers.
User Profiles
Perfect for cell counting, sizing, and analyzing microscopy images without heavy local software installations.
Analyze material structures, measure micro-cracks, and perform precise structural defect analysis on-the-fly.
Quick, accurate data collection for labs and assignments using standard images from any device.
MicroMark Pro is designed to make scientific image analysis accessible to everyone.